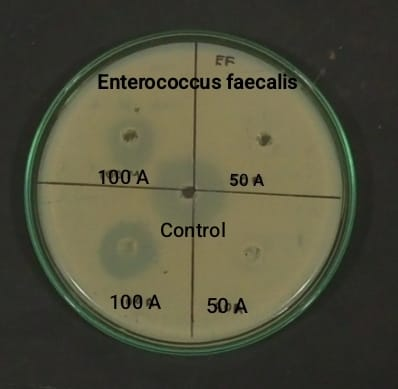
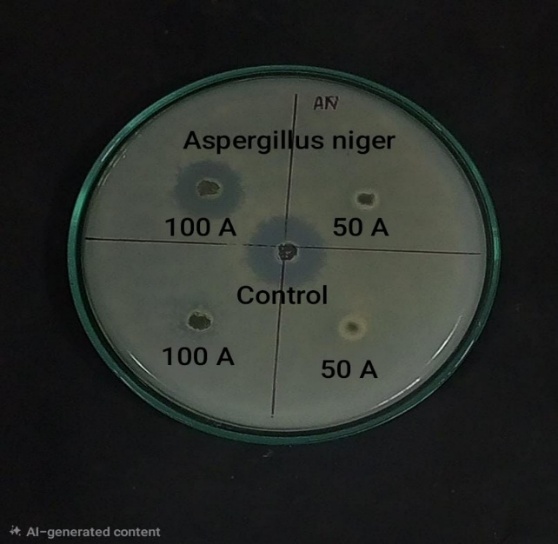
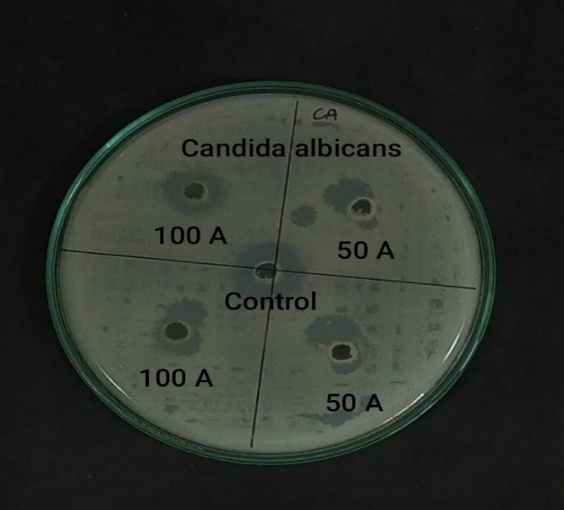

The present study explored the phytochemical composition and biological activities of the acetone extract of Alternanthera sessilis. Qualitative analysis revealed the presence of various bioactive constituents, including alkaloids, flavonoids, phenolics, glycosides, saponins, terpenoids, steroids, proteins, amino acids, and carbohydrates. The antioxidant activity, evaluated using the DPPH assay, showed a dose-dependent increase in radical scavenging ability, with maximum inhibition of 50.86% at 100 µL. Antimicrobial evaluation indicated moderate effectiveness of the extract against bacterial strains such as Enterococcus faecalis and Pseudomonas aeruginosa, as well as fungal strains including Candida albicans and Aspergillus niger. Overall, these results support the traditional medicinal use of A. sessilis and highlight its potential as a natural source of antioxidant and antimicrobial agents
Alternanthera sessilis, Phytochemicals, Antioxidant, Antibacterial, Antifungal, DPPH assay
Medicinal plants from the time immemorial used by man as traditional medicine, 80% utilized in health care and 85% for preparing herbal extracts. These plants are found in diverse habitats and the landscape. In India, almost 70 % of medicinal plants are found in tropical areas, generally in the Western and Eastern Ghats, the Chhota Nagpur plateau, the Aravallis, the Vindhyas, and Himalayan forest areas (1). Less than 30% of medicinal plants species present in the temperate, alpine areas, and at higher altitudes, these species are found to have greater medicinal properties. Researchers have identified that compared to the evergreen or temperate habitats, a higher percentage of the known medicinal plants are found in the moist and dry deciduous vegetation. Analysis of medicinal plants habits shows that these plants can thrive in diverse habitats (2). Medicinal plants are documented in total 386 families and 2,200 genera, especially the higher number of species are recorded in the families like Asteraceae, Rubiaceae, Lamiaceae, Amaranthaceae and Fabaceae and in which the Asteraceae family has the highest number of species (3). The industries use 90% medicinal plants collected from the wild. The pharmaceutical industry utilizes 800 species for drug production and for commercial cultivation only less than 20 plant species are used. About 70 percent of the plant collections comprise of destructive harvesting as the plant's roots, bark, wood, stem, and in herbs, the whole plants are used (4).
Alternanthera sessilis is a perennial herb belonging to the family Amaranthaceae and is commonly found in tropical and subtropical regions. In India, the plant is popularly known as Ponnanganni and is widely used as a leafy vegetable as well as a medicinal herb in traditional systems such as Ayurveda and Siddha medicine (5). The plant grows well in moist environments and is commonly seen near water bodies, agricultural fields and marshy lands. Traditionally, it has been used for improving eyesight, treating skin disorders, reducing inflammation and promoting liver health. Due to its nutritional and medicinal importance, this plant has gained attention in phytochemical and pharmacological research (6)
Phytochemicals are naturally occurring chemical compounds present in plants that contribute to their medicinal properties. These compounds include alkaloids, flavonoids, phenolic compounds, glycosides, saponins and terpenoids. Many of these compounds are known to possess antioxidant activity which helps in neutralizing harmful free radicals in the body. Free radicals are unstable molecules that can cause oxidative stress, leading to cell damage and various chronic diseases such as cancer, diabetes and cardiovascular disorders (7). Therefore, studying the antioxidant activity of plant extracts is important for identifying natural sources of protective compounds.
The antimicrobial activity of medicinal plants is also an important area of research due to the increasing problem of antibiotic resistance among pathogenic microorganisms. Bacterial pathogens such as Enterococcus faecalis and Pseudomonas aeruginosa are known to cause infections in humans. Similarly, fungal organisms like Candida albicans and Aspergillus niger are responsible for various fungal diseases (8). Plant extracts containing bioactive compounds may exhibit inhibitory effects against these microorganisms.
The aim of the present investigation was to determine the antioxidant, antimicrobial activity and antifungal activities of acetone extract of Alternanthera sessilis.
MATERIALS AND METHODS
Procurement and Authentication of Plant material
The fresh leaves of Alternanthera sessilis were collected from Herbal Garden at Sri Sairam Siddha Medical College and Research Centre, West Tambaram, Tamilnadu, India, Chennai, identified and authenticated by Dr. S. Sankaranarayanan, Head of the Department, Department of Medicinal Botany, Government Siddha Medical college, Arumbakkam, Chennai.
Processing of Plant material and Solvent extraction
The leaves of Alternanthera sessilis were collected, washed under running tap water followed by distilled water and shade dried for 5 days .The dried leaves were ground to fine powder and sieved. 20 g of finely grounded petals was weighed and soaked in 70% acetone at room temperature for 24 hrs. Then the extract was filtered using Whattmann filter paper No.1 and then concentrated to dryness in vacuum at 40°C-50°C (overnight) using a rotary evaporator. The residue was thoroughly mixed with acetone and used for further studies.
Phytochemical Screening
The acetone extract of Alternanthera sessilis was subjected to phytochemical screening to determine the presence of secondary metabolites such as alkaloids, flavonoids, terpenoids, tannins, glycosides, saponins and polyphenols using standard procedures (9,10).
Test for Alkaloids
The extracts were subjected to qualitative test for the identification of alkaloids
Dragendroffs Test
1 ml of each acetne extract was mixed thoroughly with 2ml of HCl. To this acidic medium 1ml of dragendroff’s reagent was added, orange or red precipitate was observed indicates the presence of alkaloids.
Test for Carbohydrate
1 ml of acetone extract was boiled in a water bath with one millilitre each of Fehling’s solution I and II. The formation of a brick-red precipitate indicated the presence of reducing sugars.
Test for glycosides
The acetone extract was hydrolyzed with Hydrochloric acid for few hours on a water bath and then the hydrolysate was subjected to Bornbager’s test for the presence of glycosides.
Bornbager’s test
The hydrolysate was treated with chloroform and carefully removes the chloroform layer. Then, the equal volume of dilute ammonia solution was added. The pink color was observed indicates the presence of glycosides.
Keller-Killani test
2 ml of acetone extract was mixed with glacial acetic acid followed by the addition of few drops of 5% Fecl3 and concentrated H2SO4. The reddish brown color appears at the junction of the two layers and the upper layer turns bluish green in color which indicates the presence of glycosides.
Test for saponins
5g of powdered sample of leaves of Alternanthera sessilis was weighed accurately, boiled in 20 ml of distilled water for few minutes and filtered. 10ml of the filtrate was mixed with 5 ml of distilled water and shaken vigorously for a stable froth formation. The formation of 2cm layer of foam was observed indicates the presence of saponins.
Test for Proteins
The extract was dissolved in 10 ml of distilled water and filtered through Whatman No.1 filter paper. The filtrate was subjected to protein tests.
Biuret Test:
A few ml of the acetone extract was treated with two percent copper sulphate solution. Ethanol was then added, followed by excess potassium hydroxide pellets. The development of a pink colour in the ethanol layer indicated the presence of proteins.
Test for aminoacids:
The presence of amino acids was tested using the ninhydrin test.
Ninhydrin Test:
The acetone extract when boiled with 2ml of 0.2% solution of Ninhydrin, purple colour appeared suggesting the presence of amino acids .
Test for Phenolic compounds :
Phenolic compounds were detected using the ferric chloride test.
Ferric Chloride Test :
The extract was dissolved in 5 ml of distilled water, and a few drops of ferric chloride solution were added. The appearance of a dark green colour confirmed the presence of phenolic compounds.
Test for flavonoids
The extracts were subjected to qualitative test for the identification of flavanoids.
Alkaline Reagent test
To 1ml of the acetone extract, a few drops of dilute sodium hydroxide were added .A intense yellow colour was observed indicates the presence of flavonoids.
Ammonia test
5 ml of dilute ammonia solution was added to 1ml of the acetone extract followed by the addition of concentrated H2SO4. The yellow colour was observed in each methanol extract of different medicinal plants indicate the presence of flavonoids. The yellow colour disappears on standing for few minutes. Few drops of 1% aluminium chloride solution were added to a portion of each filtrate. The yellow colour was observed indicating the presence of flavonoids.
Test for flavonoids
The extracts were subjected to qualitative test for the identification of flavanoids.
Ammonia test
5 ml of dilute ammonia solution was added to 1ml of the acetone extract followed by the addition of concentrated H2SO4. The yellow colour was observed in each methanol extract of different medicinal plants indicate the presence of flavonoids. The yellow colour disappears on standing for few minutes. Few drops of 1% aluminium chloride solution were added to a portion of each filtrate. The yellow colour was observed indicating the presence of flavonoids.
Test for terpenoids
The extracts were subjected to qualitative test for the identification of terpenoids
Noller’s test
Dissolve two or three granules or tin metal in thionyl chloride solution. Then add 1ml of a
acetone extract in the test tube and warm it for few minutes. The formation of pink color indicates the presence of terpenoids.
Test for Steroids:
Steroids were confirmed by treating the extract with chloroform, acetic anhydride, and sulphuric acid.
Liebermann Test:
2ml of chloroform were added to a few drops of the acetone extract, followed by a few drops of acetic anhydride. Concentrated sulphuric acid was then carefully added. The appearance of a mixture of blue or green colour indicated the presence of steroids.
Antioxidant activity :
DPPH Assay :
The radical scavenging activity of Alternanthera sessilis extracts was measured by DPPH method 13. 1 ml of 0.135mM DPPH solution in methanol was mixed with various concentrations (20-100 μl) of acetone extract. The reaction mixture was vortexed and left in the dark at room temperature for 30 min. The absorbance was measured at 517 nm. A reaction mixture without test sample was served as control. The ability to scavenge DPPH radical was calculated by the following equation:
% scavenging activity = Control Abs – Test Abs X 100 / Control Abs
Antibacterial activity :
The antibacterial potential of leaf extracts was assessed against the Gram-positive bacterium Enterococcus faecalis and the Gram-negative bacterium Pseudomonas aeruginosa. The acetone extract of A. sessilis was evaluated using the agar well diffusion technique. Sterilized nutrient agar was poured into Petri plates and allowed to solidify. Fresh overnight cultures of the test organisms were evenly spread over the agar surface using sterile cotton swabs. Wells of 6 mm diameter were aseptically punched into the agar and loaded with 50 µl and 100 µl of the extract. Gentamicin was used as the standard reference antibiotic. The plates were incubated at 37 °C for 24 hours, and the antibacterial activity was determined by measuring the diameter of the inhibition zones in millimeters (11).
Antifungal activity :
The antifungal activity of A. sessilis extracts was evaluated against the fungal strains Aspergillus niger and Candida albicans using both acetone and methanol solvents. The assay was performed by the agar well diffusion method on Potato Dextrose Agar (PDA) medium. Sterilized PDA was poured into Petri plates, and the fungal cultures were evenly spread over the surface using sterile swabs. Wells of 6 mm diameter were aseptically punched into the agar and loaded with 50 µl and 100 µl of the extracts. Clotrimazole was used as the positive control. The plates were incubated at 28 °C for 48–72 hours. Antifungal activity was determined by measuring the diameter of the zones of inhibition surrounding the wells (12,13).
RESULT
4.1 Preliminary Phytochemical Screening of Alternanthera sessilis
The preliminary phytochemical screening of leaf extract of Alternanthera sessilis revealed the presence of flavanoids, alkaloid, saponins, tannins,Proteins and aminoacids (Table.1). In previous studies, the presence of these phytochemical compounds is known to support the bioactivities of medicinal plants (14). The present study was correlated with previous report, the phytochemicals in the ethanolic extract of A. sessilis contained 6 primary compounds, such as, flavonoids tannins, polyphenols, saponins, cardiac gylcosides and quinones (15,16). The phytochemical screening and pharmacological studies were essential for discovery of novel drugs (17).


 Sumathy Rengarajan *
Sumathy Rengarajan *
 Saveetha Narayanan
Saveetha Narayanan
 Vasumathi Saravanan
Vasumathi Saravanan
 Sarany Appadurai
Sarany Appadurai

10.5281/zenodo.19333169
10.5281/zenodo.19333169